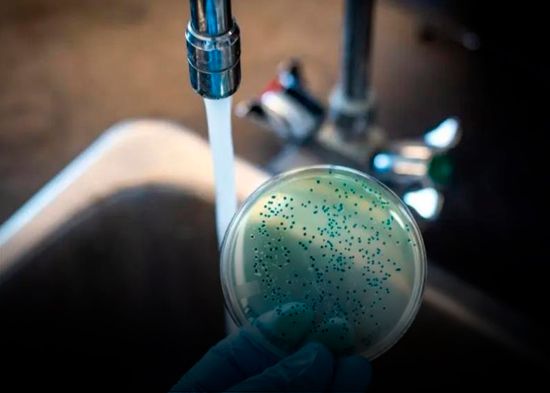

Identifican a 4 miembros de la pandilla femenina “duendes verdes”
La Policía de New York aseguró identificar a cuatro miembros de la pandilla “Duendes verdes” que atacaron brutalmente a dos mujeres de 19 años en un tren de Manhattan, y se pondrán en marcha para su búsqueda.
Leer más…Identifican a 4 miembros de la pandilla femenina “duendes verdes”